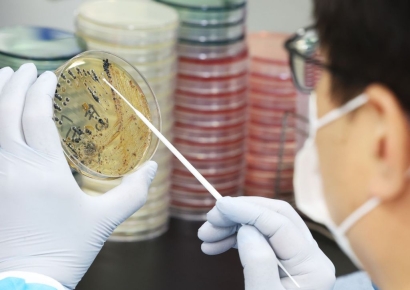
전북 남원 초중고 1000여명 식중독 증세…"김치서 노로바이러스"

"여기 중국이야?"…차이나타운 방문한 조민 당황케 한 음식
조국 조국혁신당 대표의 딸이자 인플루언서로 활동 중인 조민 씨가 예비 신랑과 함께 서울 영등포구 대림동 차이나타운 데이트를 즐겼다. 조 씨는 5일 인스타그램에 "양다리가 통째로 나올 줄 몰라서 당황"이라며 놀란 표정을 지은 사진을 공개했다. 이날을 담은 영상은 자신의 유튜브 채널 '쪼민 minchobae'에 '대림동 블로그. 여기 중국이야?'라는 제목으로 올리기도 했다. 조 씨는 올 하반기 결혼할 예정으로, 최근에는 웨딩촬영
!["엄마, 하니 구찌지갑 사주세요"…아이돌 따라 '쭉쭉' 내려가는 명품 소비 연령[디토사회]](https://cwcontent.asiae.co.kr/asiaresize/93/2024061810473320080_1718675253.jpg)
"엄마, 하니 구찌지갑 사주세요"…아이돌 따라 '쭉쭉' 내려가는 명품 소비 연령
편집자주서울대 소비트렌드분석센터가 2024년 10대 키워드 중 하나로 꼽은 '디토(Ditto) 소비'. 디토는 '마찬가지'라는 의미의 라틴어로, 디토소비는 제품을 구매하거나 콘텐츠를 소비할 때 유명인의 취향과 유행을 그대로 따라하는 경향을 뜻한다. 점차 소비 연령대가 낮아지는 명품 소비, 늘어나는 유행 편승 투자 등 한국 사회의 맹목적 '디토'들을 분석해본다. 직장인 최재인(31)씨는 올해 초 고등학생 조카로부터 명품 지갑을

"월급 222만원, 찌그러진 철밥통"…9급 공무원 초임 '최저임금' 수준
9급 초임(1호봉) 공무원 월평균 급여액이 민간 최저임금보다 16만원 많은 수준인 것으로 나타났다. 6일 전국공무원노동조합 자료를 보면 올해 9급 1호봉은 매달 본봉 187만7000원, 직급 보조비 17만5000원, 정액 급식비 14만원, 정근수당 가산금 3만원을 더해 세전 222만2000원을 받는다. 세금을 제하면 실수령액은 이보다 더 줄어든다. 이는 올해 최저시급(9860원)을 바탕으로 환산한 민간인 노동자의 월급 206만740원보다 16만12

'한국은 안 보이네'…전 세계인들 이민 가고 싶은 나라 순위 봤더니
전 세계인들이 가장 이민을 가고 싶어 하는 나라 1위는 캐나다라는 결과가 나왔다. 4일(현지시간) 뉴욕포스트는 구글 검색 데이터 분석 결과, 사람들이 가장 이주하고 싶은 나라는 캐나다로 밝혀졌다고 보도했다. 구글에서는 지난 1년 동안 150만건 이상의 '캐나다 이민' 관련 검색이 이뤄졌다. 호주는 120만건 이상의 검색 기록으로 2위에 올랐다. 3위는 뉴질랜드였으며, 스페인과 영국이 그 뒤를 이어 각각 4위와 5위에 올랐다

"최저임금 수준에 청년공무원 떠나"…공무원노조 '임금인상' 집회
공무원 노동조합들은 6일 청년 공무원들의 공직 이탈을 막기 위해 공무원 임금과 각종 수당을 인상해야 한다고 주장했다. 전국공무원노동조합·대한민국공무원노동조합총연맹·전국교직원노동조합·전국민주우체국본부·교육청노동조합연맹·전국경찰직장협의회는 이날 오후 정부서울청사 인근에서 '공무원 임금 인상 쟁취 총궐기대회'를 열고 "생활물가가 지속해 오르고 있지만 공무원은 낮은 임금 인상률로 인해 생존권을 위협받

박나래·전현무도 '냠냠'…MZ들 난리난 초록색 '두바이 초콜릿' 뭐길래
아랍에미리트(UAE)에 기반을 둔 초콜릿 브랜드 '픽스 디저트 쇼콜라티에'(픽스 초콜릿)가 선풍적인 인기를 끌고 있다. 한국에서 '두바이 초콜릿'으로 불리는 이 제품은 흘러넘칠 것 같이 가득 찬 필링, 알록달록한 디자인이 특징으로 카다이프(중동 지역의 얇은 국수)와 초록색인 피스타치오 크림을 섞어 만들었다. '두바이 초콜릿'이 본격적으로 입소문을 탄 건 한 틱톡 인플루언서가 바 형태의 초콜릿을 먹는 영상이 화제가 되면
![시청역 참변 ‘토마토 주스’ 조롱…사회적 참사 고인 모독 왜 계속되나[마감후]](https://cwcontent.asiae.co.kr/asiaresize/93/2024070509545841237_1720140898.jpg)
시청역 참변 ‘토마토 주스’ 조롱…사회적 참사 고인 모독 왜 계속되나
편집자주‘마감후’는 지면에서 미처 다루지 못한 뒷이야기를 온라인을 통해 밀도 있게 전달합니다. 모두가 기억하는 결과인 속보, 스트레이트, 단신 기사에서 벗어나, 그간의 스토리, 쟁점과 토론 지점, 찬반양론 등을 다양한 시각물과 함께 보여드립니다. 서울 시청역 역주행 사고로 9명이 사망한 참변이 일어난 가운데, 고인 추모 공간에 ‘토마토 주스가 된 분들’이라고 적힌 쪽지가 남겨져 파문이 일고 있다. 피해자들을 패

또 차량 인도 돌진해 행인 2명 부상…고령운전자 '급발진' 주장
6일 고령 운전자가 몰던 차량이 서울역 인근에서 인도로 돌진해 보행자 2명이 다쳤다. 경찰은 '급발진 여부'를 조사할 예정이다. 경찰에 따르면 80대 남성 A씨의 차가 이날 오전 9시 20분쯤 서울역 인근 주유소에서 나와 인도로 돌진했다. 보행자 2명이 A씨의 차에 치여 인근 병원으로 이송됐다. A씨 차량은 행인을 잇달아 친 뒤 건물 벽을 들이받고 '돌진'을 멈춘 것으로 알려졌다. 한 목격자는 "(사고 당시) 부아앙, 쾅 소리가

항상 먹던 아메리카노 갑자기 '비릿'…이유 찾아보니 '경악'
카페 여직원이 마시던 음료에 몰래 정체불명의 이물질을 주입한 남성 손님이 매장 내부 폐쇄회로(CC)TV에 포착돼 경찰이 추적에 나섰다. 5일 JTBC '사건반장'은 지난 2일 오후 서울 용산구의 한 카페에서 찍힌 CCTV 영상을 공개했다. 제보자인 카페 직원 A씨는 이날 혼자 근무하던 중 자신이 마시던 커피를 내려뒀다가 잠시 후 다시 마셨는데 역한 비린내를 느껴 곧바로 음료를 모두 뱉었다고 전했다. A씨는 "아이스 아메리카노를

"온갖 이유로 AV 공연 막더니…19금쇼는 되나" 뿔난 남성들
여성 관객을 겨냥한 미국 라스베이거스의 성인 뮤지컬이 지난달 말 서울 공연을 마친 가운데, 온라인상에서 일본 AV(성인영화) 여배우가 출연하는 국내 행사가 무산된 것과 비교하며 형평성에 어긋난다는 주장이 나오고 있다. 이달 한 온라인 커뮤니티에서는 네티즌이 "서울시가 온갖 이유를 들며 일본 AV 출연 공연을 거부하더니 상탈(상의 탈의) 공연인 외국 남성 팀 내한 뮤지컬 '썬더 프롬 다운 언더(Thunder From Down Under)









![[속보]삼성동서 화학물질 누출 의심…8명 병원서 처치](https://cwcontent.asiae.co.kr/asiaresize/93/2024032815261921258_1711607179.jpg)